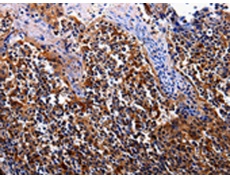
一抗

|
Background: |
This gene encodes a single-pass type I membrane protein that shares similarity with the interleukin-17 receptor (IL-17RA). Unlike IL-17RA, which is predominantly expressed in hemopoietic cells, and binds with high affinity to only IL-17A, this protein is expressed in nonhemopoietic tissues, and binds both IL-17A and IL-17F with similar affinities. The proinflammatory cytokines, IL-17A and IL-17F, have been implicated in the progression of inflammatory and autoimmune diseases. Multiple alternatively spliced transcript variants encoding different isoforms have been detected for this gene, and it has been proposed that soluble, secreted proteins lacking transmembrane and intracellular domains may function as extracellular antagonists to cytokine signaling. |
|
Applications: |
ELISA, IHC |
|
Name of antibody: |
IL17RC |
|
Immunogen: |
Fusion protein of human IL17RC |
|
Full name: |
Interleukin-17 receptor C |
|
Synonyms: |
IL17RL |
|
SwissProt: |
Q8NAC3 |
|
ELISA Recommended dilution: |
1000-5000 |
|
IHC positive control: |
Human tosil |
|
IHC Recommend dilution: |
25-100 |

 購(gòu)物車
購(gòu)物車 幫助
幫助
 021-54845833/15800441009
021-54845833/15800441009